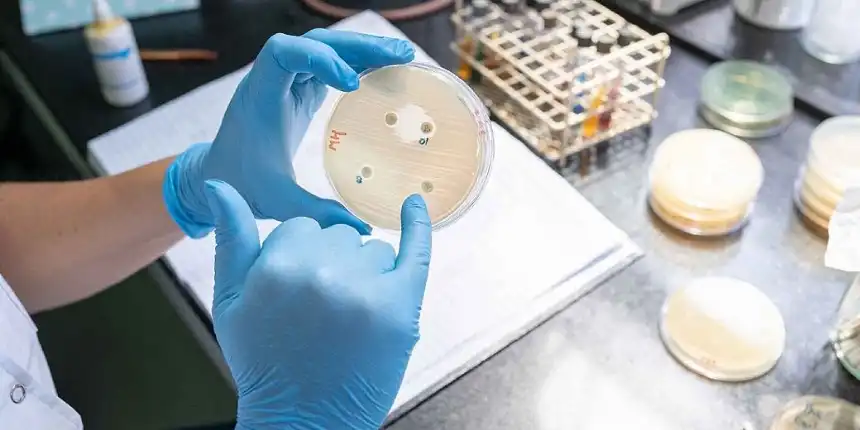

Se trata de una iniciativa destinada a promover actividades científicas y tecnológicas e impulsar el federalismo.
La Plata, 21 de noviembre de 2025.- El Gobierno de la provincia de Buenos Aires dio a conocer los resultados del tramo preparatorio de los Proyectos Bonaerenses de Federalización de la Ciencia y la Tecnología, una iniciativa que consolida la construcción de redes científicas con alcance nacional y que fue impulsada de manera conjunta por la Comisión de Investigaciones Científicas y el Ministerio de Gobierno de la provincia de Buenos Aires.
En esta instancia fueron seleccionados proyectos presentados por 34 universidades de todo el país, de las cuales 20 tienen asiento en el territorio bonaerense y articularon con 14 universidades nacionales de otras provincias, a fin de fortalecer un entramado federal orientado a la investigación, el desarrollo y la transferencia de conocimiento para dar respuestas a problemáticas de interés común. Las propuestas se estructuraron en redes federales de investigación integradas por nodos académicos de diferentes regiones.
¿Cuáles son las temáticas de los proyectos seleccionados?
Las temáticas seleccionadas se enmarcan en áreas definidas como prioritarias que reflejan una mirada integral sobre los desafíos productivos, sociales, ambientales y sanitarios, poniendo el valor de la ciencia como herramienta para el desarrollo sostenible y la formulación de políticas públicas. Las áreas a trabajar serán:
Acceso y manejo de recursos hídricos
Cambio climático y ambiente
Empleo y juventud
Energía y transición energética
Estudios del mar
Federalismo
Salud: cannabis y dengue-arbovirus
Los proyectos fueron seleccionados por una comisión evaluadora integrada por pares especialistas en cada área del conocimiento, quienes analizaron las propuestas en función de su calidad científica, pertinencia territorial, impacto y coherencia.
Federalización de la ciencia
Con esta convocatoria, el Gobierno bonaerense consolida su estrategia de federalización del conocimiento, promoviendo el trabajo colaborativo entre las universidades nacionales y provinciales asentadas en territorio bonaerense y casas de altos estudios localizadas en otras doce provincias. Las instituciones participantes son la Universidad de Buenos Aires, la Universidad Nacional Arturo Jauretche, la Universidad Nacional de Chilecito, la Universidad Nacional de Córdoba, la Universidad Nacional de Entre Ríos, la Universidad Nacional de General Sarmiento, la Universidad Nacional de Hurlingham, la Universidad Nacional de José C. Paz, la Universidad Nacional de Jujuy, la Universidad Nacional de La Pampa, la Universidad Nacional de la Patagonia Austral, la Universidad Nacional de La Plata, la Universidad Nacional de Lanús, la Universidad Nacional de Luján, la Universidad Nacional de Mar del Plata, la Universidad Nacional de Misiones, la Universidad Nacional de Moreno, la Universidad Nacional de Pilar, la Universidad Nacional de Quilmes, la Universidad Nacional de Río Negro, la Universidad Nacional de San Antonio de Areco, la Universidad Nacional de San Juan, la Universidad Nacional de San Luis, la Universidad Nacional de San Martín, la Universidad Nacional de Tierra del Fuego, la Universidad Nacional de Tres de Febrero, la Universidad Nacional de Tucumán, la Universidad Nacional del Centro de la Provincia de Buenos Aires, la Universidad Nacional del Comahue, la Universidad Nacional del Delta, la Universidad Nacional del Sur, la Universidad Nacional Guillermo Brown, la Universidad Provincial del Sudoeste y la Universidad Tecnológica Nacional.
De esta forma, la Provincia reafirma su compromiso con el sostenimiento del sistema científico-tecnológico en un contexto de fuerte retracción del financiamiento proveniente del Gobierno nacional. Cabe recordar que la inversión en ciencia y tecnología a nivel nacional se encuentra en sus mínimos históricos en relación al PBI (0,153%), peor que en la última dictadura y que durante la crisis económica de 2002. A su vez, la subejecución presupuestaria por parte del Gobierno nacional en esta área alcanzó el récord de 13% en 2024.
Min. Gob. PBA